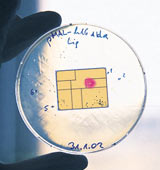

Die Gefahr, die von Chipkarten ausgeht wird von kriminellen Elementen totgeschwiegen.
Wir klären auf und können Sie retten!
Die geheim gehaltene Gefahr: Chipkarten-Viren
Monopolistische Geldinstitute wissen schon lange um die Gefahr und Auswirkungen der Chipkarten -Viren und sind großzügig und diskret, wenn es um Schadenersatz geht. Hauptsache, der Betrug fällt nicht weiter auf.
Doch für Betroffene sind die Auswirkungen nur schwer erkennbar und ein Nachweis oft unmöglich:
- Gedächtnisverlust im Umgang mit Zahlen
- Unaufmerksamkeit bei Finanz-Aktionen (Bezahlen, Wechselgeld nachzählen)
- Schwäche bei Preisvergleichen
- Kontrollverlust über Ausgaben
- Impotenz
- Alzheimer
- Entmündigung
Obwohl Banken nicht bezeugen, dass sie geheime Studien haben, die das klar und deutlich nachweisen, wird darüber geschwiegen, denn schließlich sind die Banken die Hauptgewinner!
Weiter:
Wie funktionieren Chipkarten -Viren
Wie verbreiten sie sich?